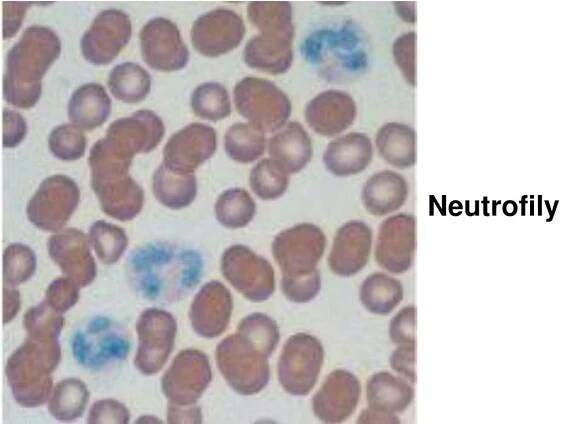
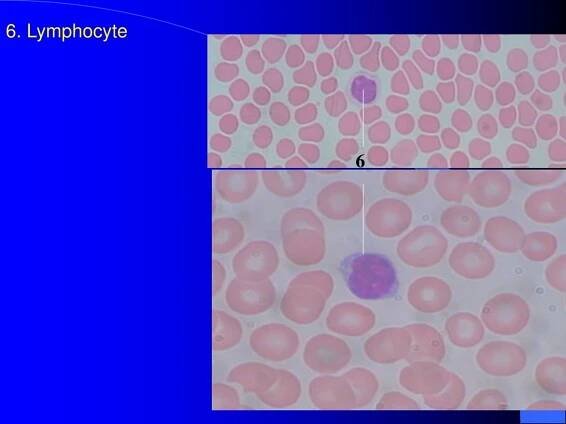
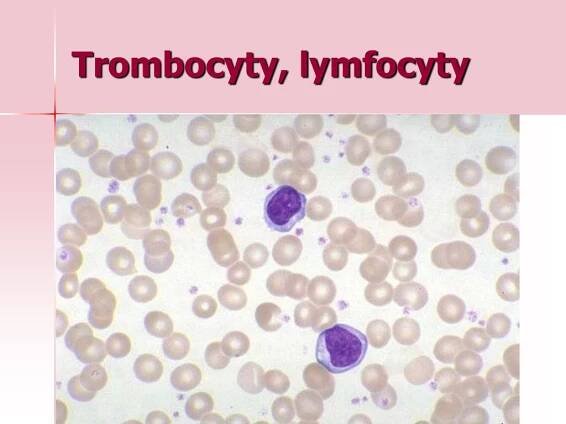

Bílá krvinka – Wikipedie
Bílá krvinka či leukocyt je krevní buňka mnohých živočichů, která se obvykle podílí na fungování imunitního systému. Bílé krvinky zpravidla mají schopnost bojovat proti virům, bakteriím a jiným patogenům či částicím, ale i nádorovým buňkám a…
Krevní obraz – leukocyty (WBC)
Biochemie, molekulární biologie, imonulogie, cytometrie, cytogenetika, mikrobiologie
leukocyty (bílé krvinky) » Linkos.cz
Leukocyty jsou souhrnné označení různých druhů bílých krvinek. Jejich počet hodnotí krevní obraz. Ve výsledcích vyšetření jsou někdy uváděny pod anglickou zkratkou WBC (white blood cells = bílé krevní buňky).
Váš poradce pro lidské zdraví » Medixa.org
Informační portál zaměřený na zdraví.
Neobsahuje 2Musí obsahovat 2
Leukocyty a jejich význam pro naše zdraví | Europlasma
Zjistěte co jsou leukocyty, jaké jsou jejich normální hodnoty a co mohou pro naše zdraví znamenat případné odchylky od těchto hodnot.
Neobsahuje 2Musí obsahovat 2
leukocyty | NZIP
Leukocyty neboli bílé krvinky jsou součástí krve a řadí se mezi buňky imunitního systému. Bílé krvinky společně s krevními destičkami tvoří méně než 1 % objemu ...
Leukocyty v moči mohou být varováním před infekcí | Ferwer
Leukocyty v moči mohou signalizovat infekci močových cest či jiný problém. Co prozradí rozbor moči a krevní test? Naučte se rozpoznat důležité příznaky!
Neobsahuje 2Musí obsahovat 2
odkazuje na služby nejen od Seznam.cz.
© 1996–2025 Seznam.cz, a.s.